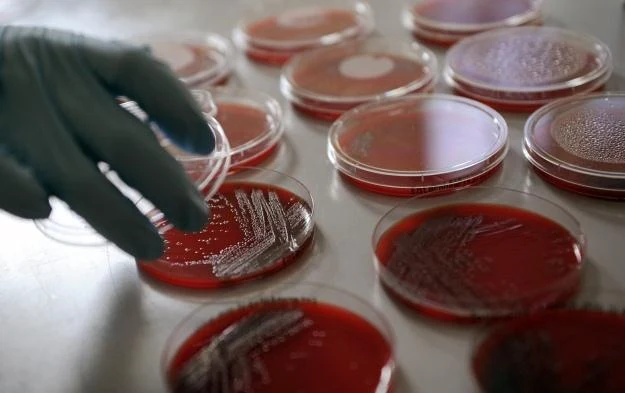

Bakteria E. coli jako pojemny nośnik danych
W DNA zapisane są wszystkie informacje na temat tego, jak ma wyglądać, funkcjonować i rozwijać się nasz organizm. To zupełnie nieprawdopodobna ilość danych, zwłaszcza, że ich nośnik jest raczej niewielkich rozmiarów. No właśnie: nośnik. Czy da się na nim zapisać inne informacje? Naukowcy udowodnili, że owszem.
Badacze z Uniwersytetu w Standforda postanowili sprawdzić, czy tak pojemny nośnik informacji, z którego korzystają wszystkie żywe organizmy da się dostosować do potrzeb naszych komputerów. Do testów wybrana została dobrze znana bakteria E-coli. Przez ostatnie trzy lata pracowano nad taką jej modyfikacją, aby możliwe stało się wykorzystanie zawartego w mikrobie DNA do zapisywania i przechowywania poszczególnych bitów informacji.
Sam zapis jest dość nietypowy: bity zapisane są w formie sekwencji barwnych, jarzących się fragmentów DNA, w dwóch kontrastowych kolorach - czerwonym i zielonym. Dzięki temu zakodowaną wcześniej informację można następnie dość łatwo odczytać.
Współtwórca tej metody, bioinżynier Drew Endy, widzi dla nośników genowych bardzo szerokie możliwości zastosowania.
Wykorzystanie w przyszłości systemów biologicznych jako stabilnego magazynu pamięci do komputerów jest jego zdaniem nie tylko całkiem prawdopodobne, ale i celowe. Gromadzimy przecież coraz większe ilości informacji i aktualnie stosowane nośniki po prostu przestają nam wystarczać.
Kira










